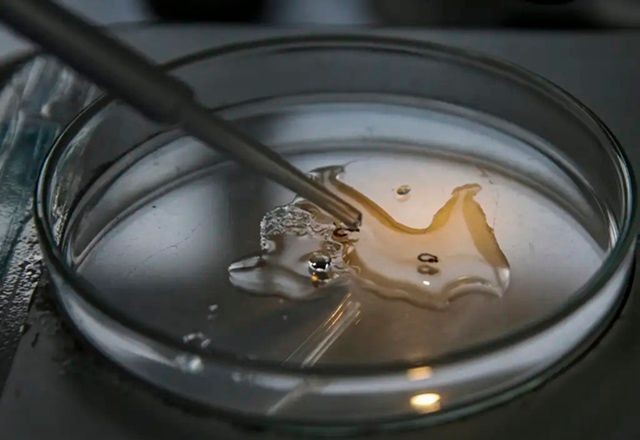

Estudo detecta vírus zika e chikungunya em ovos de mosquitos Aedes
Pesquisa evidencia urgência de medidas de controle e prevenção mais eficazes contra o Aedes aegypti
Lucas Barbosa
Pesquisadores da Universidade Federal de Goiás (UFG) identificaram ovos do mosquito Aedes aegypti já infectados pelos vírus da zika (ZIKV) e da chikungunya (CHIKV). O resultado demonstra a transmissão vertical do vírus, quando é passado de fêmeas adultas para larvas depositadas por elas. Posteriormente, os ovos eclodem e os novos mosquitos já nascem com o vírus recebido.
+ Estado do Rio de Janeiro tem 26 mortes registradas por dengue
A descoberta sugere que a disseminação das doenças pode ocorrer de forma mais rápida e independente do contato prévio do mosquito com pessoas infectadas, uma vez que os mosquitos já podem nascer carregando os vírus. "Não necessariamente a gente precisa encontrar outras pessoas infectadas pelo Aedes se contaminar. É como se a dinâmica agora fosse mais rápida", explica Juliana Santana de Curcio, pesquisadora da UFG.
A pesquisa coloca em evidência a urgência de medidas de controle e prevenção mais eficazes contra o Aedes aegypti, especialmente em um momento em que pelo menos sete estados brasileiros já declararam estado de emergência devido ao aumento de casos das doenças. O estudo reforça a importância do manejo ambiental, como a eliminação de criadouros do mosquito, para prevenir a eclosão de ovos infectados.
Flúvia Amorim, superintendente de vigilância em saúde de Goiás, destaca a priorização do trabalho de manejo ambiental. "É mais um motivo que a gente vem priorizando o trabalho de manejo ambiental, que é limpeza mesmo, retirar criadouros que possam ter ovos ali e evitar que esse mosquito nasça. Essa é a principal ação de cada um: governos municipais, estaduais e a população", afirma Amorim.